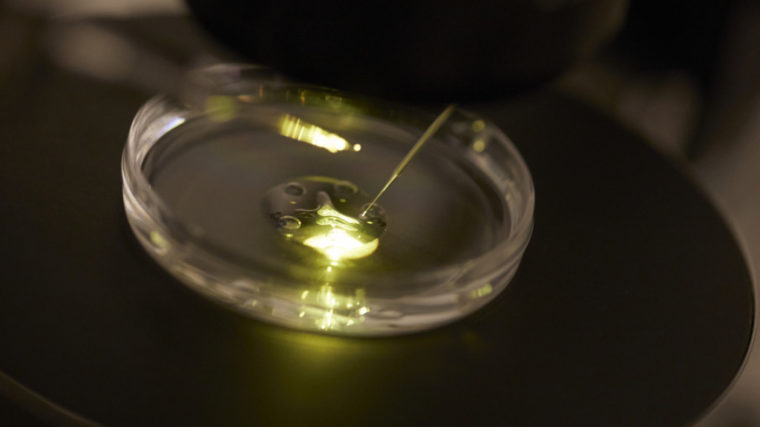

Das Stimmvolk hat die Verfassungsänderung zur Präimplantationsdiagnostik (PID) mit 61,9 Prozent angenommen. Für die Zulassung der PID muss aber zuerst die vom Parlament beschlossene Gesetzesänderung in Kraft gesetzt werden. Hierzu plant die EVP das Referendum.
Wie EVP-Präsidentin Marianne Streiff am Sonntag ankündigte, wird die Evangelische Volkspartei gegen das PID-Gesetz das Referendum ergreifen. Sie hat dafür die EVP 100 Tage Zeit, nachdem das vom Parlament fertig beratene Gesetz im Bundesblatt veröffentlicht wurde.
Ständerat Felix Gutzwiller (FDP/ZH) zeigte sich am Sonntag optimistisch, auch das Referendum über das PID-Gesetz gewinnen zu können. Er gehe davon aus, dass bei einer Referendumsabstimmung das Ergebnis noch deutlicher zu Gunsten der Befürworter ausfallen werde, sagte er zu Nachrichtenagentur sda.
Auch Gesundheitsminister Alain Berset erinnerte vor den Bundeshausmedien daran, dass die Verfassungsänderung erst eine Voraussetzung für die PID schaffe. Zugelassen werde letztere erst mit der Änderung des Fortpflanzungsmedizingesetzes, und das werde nicht morgen oder nächste Woche geschehen.
Mit dem klaren Ja vom Sonntag zeigte sich Berset zufrieden. Das Resultat zeige, dass man auch über extrem komplexe Themen eine öffentliche Diskussion führen könne. Die nötige Reife sei vorhanden. «Die Mehrheit will PID, aber mit klaren Grenzen.»
Erster Schritt gemacht
Die Verfassungsänderung legt die Grundlage für die Untersuchung künstlich befruchteter Embryos vor der Einpflanzung in den Mutterleib. Formell ging es erst um die Anzahl Embryos, die im Reagenzglas gezeugt werden dürfen.
Heute erlaubt die Verfassung so viele, wie der Frau sofort eingepflanzt werden können. In der medizinischen Praxis sind das höchstens drei. Damit sind die Untersuchungen aber nicht sinnvoll durchzuführen.
Künftig erlaubt die Verfassung daher die Befruchtung so vieler Eizellen, wie «für die medizinisch unterstützte Fortpflanzung notwendig sind». Aus medizinischer Sicht wäre damit der Weg frei für die PID.
Tiefer Röstigraben
Die Abstimmung fiel deutlicher aus als erwartet. Rund 1’374’800 Personen legten ein Ja in die Urne, 845’900 sagten Nein. Die Stimmbeteiligung lag bei 42,2 Prozent. Bei der letzten Umfrage Ende Mai hatten die Befürworter noch einen so geringen Vorsprung gehabt, dass keine Prognose möglich war.
Von den 23 Standesstimmen entfielen 17 ganze und 3 halbe auf die Verfassungsänderung. Geschlossen und mit grossen Mehrheiten stimmte die Westschweiz der Verfassungsänderung zu: In der Waadt sagten 84,8 Prozent Ja, in Genf 82,2 Prozent, in Neuenburg 75,2 Prozent, gefolgt von den Kantonen Jura und Freiburg. Der erste Deutschschweizer Kanton im Ja-Lager ist Zürich mit 64,8 Prozent Ja.
Skeptisch waren kleine und ländliche Kantone. Mit 55,8 Prozent Nein-Stimmen lehnte Obwalden die Präimplantationsdiagnostik am deutlichsten ab, gefolgt von Appenzell Innerrhoden mit 55,5 Prozent. Im Nein-Lager sind auch Uri, Appenzell Ausserrhoden, Schwyz und Schaffhausen.
Anspruchsvolle Abwägung
Die Vorlage spaltete nicht Landesteile, sondern auch die Parteien. Gegen den Widerstand kirchlicher Kreise hatte die CVP Annahme empfohlen, ebenso FDP, BDP, Grüne und GLP. Die SP beschloss Stimmfreigabe, die SVP empfahl trotz vieler befürwortender Stimmen ein Nein. Beide Lager warben denn auch mit bunt besetzten Komitees für ihre Sache.
Bereits die Debatte im Parlament hatte gezeigt, dass es nur wenigen gelingt, Präimplantationsdiagnostik ideologisch oder rein rational zu beurteilen. Viele Ratsmitglieder fochten Gewissenskonflikte aus, obwohl sie die guten Argumente für die Zulassung der Untersuchungen durchaus anerkannten.
Gegen PID-Tourismus
Dazu gehört zunächst, dass die Wahrscheinlichkeit einer erfolgreichen Schwangerschaft viel grösser ist, wenn der Frau ein gesundes Embryo eingepflanzt wird. Das erspart den Eltern die Belastung von erfolglosen Behandlungszyklen und Mehrlingsschwangerschaften.
Zudem wird dem so genannten PID-Tourismus ein Riegel geschoben. Viele Frauen umgehen heute die strengen Schweizer Gesetze, indem sie sich im Ausland behandeln lassen. Und schliesslich wird der Widerspruch aufgelöst, dass Embryos zwar nicht im Reagenzglas, aber später im Mutterleib untersucht werden dürfen. Geschädigte Embryos werden dann oft abgetrieben, weshalb von «Schwangerschaft auf Probe» die Rede ist.
Gegen Designer-Babys
Kirchliche Kreise und Skeptiker der «grenzenlosen Machbarkeit» hingegen warnen vor Eugenik und vom «Zwang zum gesunden Kind». Sie wollen nicht zulassen, dass zwischen lebenswertem und lebensunwertem Leben unterschieden wird.
Das könne dazu führen, dass Kranke und behinderte Kinder künftig als vermeidbares Risiko und als Belastung angesehen würden. Auch von «Designer-Babys» war die Rede. Leid lasse sich lindern, aber nicht aus der Welt schaffen, argumentieren die Gegner.